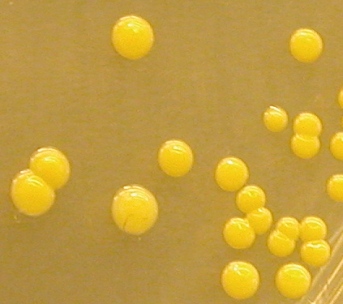

![]()
Nanomundos, Nanominerales, Ciencias de la Tierra, Biosfera, Suelos y Nanoedafología
En una época marcada por las promesas de la nanotecnología no debe extrañarnos que los científicos comiencen a preocuparse por el nanouniverso que nos rodea. Más de 30.000 páginas Web se han hecho eco del artículo publicado en la revista Nature y que lleva por título: «Nanominerals, Mineral Nanoparticles, and Earth Systems”, en el que por cierto figura al menos un edafólogo. Y sinceramente, no creo que sea una coincidencia de que este “Doland L. Sparks” sea el máximo responsable de la Iniciativa denominada Zona Crítica Terrestre, sobre la que ya hemos escrito y volveremos a hacerlo. Así, el encabezamiento que ofrece el boletín de noticias “Sciencedaily” (‘Nanominerals’ Influence Earth Systems From Ocean To Atmosphere To Biosphere), nos informa de que: “la ubicuidad y abundancia de las partículas minerales de escala nanométrica, en océanos, ríos, suelos y células vivas, suministran a los investigadores una nueva vía para la comprensión de la estructura y funcionamiento del planeta tierra. Los procesos físicos, químicos y biológicos de la Tierra están condicionados o conducidos por las propiedades que atesoran estos ”nanominerales”. ¿Ciencia de la buena, novedad, moda, viejo vino en nievas botellas?. Probablemente sea aun prematuro extraer conclusiones al respecto. En cualquier caso, y como afecta al mundo la edafología, veamos que nos dicen.

Todo indica que el punto caliente del artículo reside en enfatizar que las propiedades de los minerales a escalas nenométricas dependen tanto o más de sus tamaños, morfologías y topografías (“nanorelieve”) que de su composición química, algo que puede resultar sorprendente a muchos, aunque no a mí personalmente si os acordáis de los post que escribí sobre el dilema de la medida, en general, y de los suelos, en particular. Dicho de otro modo, los autores señalan que tamaño u forma incrementa en importancia al descender al mundo nanométrico, respecto al micro y mesoscópico. Las repercusiones de tales estudios dicen que afectará a los estudios biogeosféricos, cambio climático, geomedicina, salud pública, nanotecnología, contaminación, etc., etc.
Efectos antibacterianos de algunos nanominerales
Resumiendo, como en otras facetas de la vida, el tamaño en este caso también parece ser muy importante ¿?
Juan José Ibáñez

A bacteria cell living in a no-oxygen environment
«breathes» using mineral nanoparticles.
(Credit: Saumyaditya Bose, Virginia Tech)

Logo de Un Grupo de Trabajo Sobre Nanomineralogía
Resumen del artículo publicado en Science
Nanominerals, Mineral Nanoparticles, and Earth Systems
Michael F. Hochella, Jr.,1* Steven K. Lower,2 Patricia A. Maurice,3 R. Lee Penn,4 Nita Sahai,5 Donald L. Sparks,6 Benjamin S. Twining7
Minerals are more complex than previously thought because of the discovery that their chemical properties vary as a function of particle size when smaller, in at least one dimension, than a few nanometers, to perhaps as much as several tens of nanometers. These variations are most likely due, at least in part, to differences in surface and near-surface atomic structure, as well as crystal shape and surface topography as a function of size in this smallest of size regimes. It has now been established that these variations may make a difference in important geochemical and biogeochemical reactions and kinetics. This recognition is broadening and enriching our view of how minerals influence the hydrosphere, pedosphere, biosphere, and atmosphere.
Sciencedaily
The way in which these infinitesimally small minerals influence Earth’s systems is more complex than previously thought, the scientists say. «This is an excellent summary of the relevance of natural nanoparticles in the Earth system,» said Enriqueta Barrera, program director in NSF’s Division of Earth Sciences. «It shows that there is much to be learned about the role of nanominerals, and points to the need for future research.»
Nanoparticles play an important role in the lives of ocean-dwelling phytoplankton, for example, which remove carbon dioxide from the atmosphere. Phytoplankton growth is limited by iron availability. Iron in the ocean is composed of nanocolloids, nanominerals, and mineral nanoparticles, supplied by rivers, glaciers and deposition from the atmosphere. Nanoscale reactions resulting in the formation of phytoplankton biominerals, such as calcium carbonate, are important influences on oceanic and global carbon cycling. In addition to growth and weathering, mineral nanoparticles can be generated from mechanical grinding. One of the most interesting and important places where this happens is along earthquake-generating faults in the Earth’s crust.
There is a distinction between clusters of atoms and nanoparticles, Hochella said. «The difference seems to be that clusters start to approach the size of the smallest nanoparticles, but the atoms in many of these small clusters are not packed very tightly together. They are not dense. The nanoparticles represent a much denser packing of atoms, more like a real mineral, or at least approaching the atomic packing density of a larger mineral.»
On land, nanometer-scale hematite catalyzes the oxidation of manganese, resulting in the rapid formation of minerals that absorb heavy metals in water and soils. The rate of oxidation is increased when nanoparticles are present.
Conversely, harmful heavy metals may disperse widely, courtesy of nanominerals. (…) nanomineral involved in the movement of lead, arsenic, copper, and zinc through hundred of miles of
In the atmosphere, mineral nanoparticles impact heating and cooling. Such particles act as water droplet growth centers, which lead to cloud formation. The size and density of droplets influences solar radiation and cloud longevity, which in turn influence average global temperatures.
«The biogeochemical and ecological impact of natural and synthetic nanomaterials is one of the fastest growing areas of research, with not only vital scientific, but also large environmental, economic, and political consequences,» the authors conclude. (..)
This work was funded by the National Science Foundation. Adapted from materials provided by National Science Foundation.
«Nanominerals» Influence Earth Systems from Ocean to Atmosphere to Biosphere
(…) The way in which these infinitesimally small minerals influence Earth’s systems is more complex than previously thought, the scientists say. Their work is funded by the National Science Foundation (NSF). (….) Minerals have an enormous range of physical and chemical properties due to a wide range of composition and structure, including particle size. Each mineral has a set of specific physical and chemical properties. Nanominerals, however, have one critical difference: a range of physical and chemical properties, depending on their size and shape. «This difference changes our view of the diversity and complexity of minerals, and how they influence Earth systems,» (…) The role of nanominerals is far-reaching, said Hochella. Nanominerals are widely distributed throughout the atmosphere, oceans, surface and underground waters, and soils, and in most living organisms, even within proteins.
Nanoparticles play an important role in the lives of ocean-dwelling phytoplankton, for example, which remove carbon dioxide from the atmosphere. Phytoplankton growth is limited by iron availability. Iron in the ocean is composed of nanocolloids, nanominerals, and mineral nanoparticles, supplied by rivers, glaciers and deposition from the atmosphere. Nanoscale reactions resulting in the formation of phytoplankton biominerals, such as calcium carbonate, are important influences on oceanic and global carbon cycling.
On land, nanometer-scale hematite catalyzes the oxidation of manganese, resulting in the rapid formation of minerals that absorb heavy metals in water and soils. The rate of oxidation is increased when nanoparticles are present.
Conversely, harmful heavy metals may disperse widely, courtesy of nanominerals. In research at the Clark Fork River Superfund Complex in Montana, Hochella discovered a nanomineral involved in the movement of lead, arsenic, copper, and zinc through hundred of miles of Clark River drainage basin.
Nanominerals can also move radioactive substances. Research at one of the most contaminated nuclear sites in the world, a nuclear waste reprocessing plant in Mayak, Russian, has shown that plutonium travels in local groundwater, carried by mineral nanoparticles.
In the atmosphere, mineral nanoparticles impact heating and cooling. Such particles act as water droplet growth centers, which lead to cloud formation. The size and density of droplets influences solar radiation and cloud longevity, which in turn influence average global temperatures.
«The biogeochemical and ecological impact of natural and synthetic nanomaterials is one of the fastest growing areas of research, with not only vital scientific, but also large environmental, economic, and political consequences,» the authors conclude (..). In addition to Hochella, authors of the paper are Steven Lower of Ohio State University, and Patricia Maurice of the University of Notre Dame; along with R. Lee Penn of the University of Minnesota; Nita Sahai of the University of Wisconsin-Madison; Donald Sparks of the University of Delaware; and Benjamin Twining of the University of South Carolina.
En los siguientes artículos también se habla en el texto sobre nanominerales. Os muestro resúmenes y enlaces para los que puedan estar interesados en el tema.
Sobre nanominerales y óxidos de Hierro
Mineralogy and Petrology Journal
Natural Fe-oxide and -oxyhydroxide nanoparticles: an EPR and SQUID investigation
C. Carbone1, F. Di Benedetto2, P. Marescotti1, C. Sangregorio3, L. Sorace3, N. Lima3, M. Romanelli3, G. Lucchetti1 and C. Cipriani2
Summary Magnetic hematite (a-Fe2O3) and goethite (a-FeOOH) nanoparticles, formed in the abandoned Libiola Mine (Liguria, Italy) as a result of Acid Mine Drainage (AMD) processes that involved sulfide-bearing rocks and sulfide-rich waste material, were investigated through the study of their magnetic properties in combination with electron paramagnetic resonance (EPR) spectroscopy. Both techniques revealed that the behaviour of the nanominerals involved was predominantly superparamagnetic. In contrast, the bulk antiferromagnetic behaviour of both hematite and goethite was substantially reduced. The observed magnetic properties reflected a great variability in the particle dimensions and confirmed that both nanominerals were the transformation products of a metastable amorphous species.
Moreover, two peculiar phenomena were hypothesised: the transformation to hematite may occur before the coarsening of the amorphous transient and hematite and goethite can interconvert without intermediate crystallisation of metastable precursors. Goethite, in fact, appears to be formed as an alteration product of hematite, after a drastic change of the physico-chemical boundary conditions.
Sobre Nanoarcillas y Geomedicina
Minerals and clay minerals in medical geology en Applied Clay Science
Celso de Sousa Figueiredo Gomes, a,
and João Baptista Pereira Silvaa
aCentro de Investigação “Minerais Industriais e Argilas” da Fundação para a Ciência e a Tecnologia (FCT), Universidade de Aveiro, 3810-193 Aveiro, Portugal
Abstract
Medical geology is an emergent field of science that for some authors deals with the relationships between the geological environment and health problems in humans, animals and plants. Chemical elements, minerals, rocks, soils, water and air are the essential components of the geologic environment. Both quality and quantity of these components condition very much the living quality and the life duration, due to the beneficial and hazardous effects they have upon organisms, man, other animals, and plants. Medical geology is a multidisciplinary scientific field shared by specialists of distinct areas and scientific domains, such as earth sciences, environmental sciences, medicine, public health, biology, biochemistry, chemistry, pharmacy, nutrition, and others. Certain diseases are attributed to several minerals sensu latu (concept that includes the minerals sensu restrictu considered as natural, inorganic and crystalline solids, the so-called oligoelements or trace minerals, the biominerals and mineral resources such as natural mineral water), naturally or humanly derived. Within minerals, clay minerals, the essential constituents of clays, are omnipresent at the earth surface where organisms live, and due to their specific properties they can interact, positively as a rule, with them. Some clay minerals are being used, either as active principles (gastrointestinal protectors, laxatives, antidiarrhoeaics), or as excipients (inert bases, emulsifiers, lubricants) in certain medicines. Also they participate in formulations used for topical applications in both dermopharmacy and dermocosmetics.
Sobre la química superficial de los nanominerales y contaminación
Cu2+ as a Probe for Nanomineral Surface Chemistry
Madden, A S and Hochella, M F
Recent field-based studies have shown that minerals with diameters less than approximately 10-15 nanometers, including highly crystalline materials, are common and important in the transport of toxic metals released as a result of mining activities. Through the scientific discipline of nanoscience, it is expected that materials will experience size-property-reactivity relationships in this size range. These relationships are almost entirely unknown in mineralogical and biogeochemical systems. As such, model systems were utilized to explore nanomineral reactivity as a function of mineral size. Size-dependent geochemical reactivity of hematite nanoparticles has been measured in experimental systems, including heterogeneous Mn2+ oxidation and photochemical reduction. In general, those particles with average diameters of 7 nm have significantly greater reactivity compared to particles with average diameters greater than approximately 10 nm, even after surface area normalization. It was hypothesized that the increased reactivity of the smallest particles could be most easily interpreted as a change in the arrangement and/or coordination of surface atoms. Sorption experiments at low Cu2+ loading demonstrated an enhanced affinity of Cu2+ to the 7 nm average diameter particles relative to larger sizes, suggesting an abundance of binding sites which stabilize the Jahn-Teller distorted Cu2+ ion that are not as significant on larger sized particles. In addition, FTIR spectra of dried hematite nanominerals are consistent with an increased proportion of bidentate vs. monodentate carbonate surface complexes, representing a change in the dominant type of adsorption complex between the carbonate ion and the smallest and larger hematite particles. FTIR results along with zeta potential measurements lend further support to the hypothesis that the greater affinity of Cu2+ for the smallest particles is due to changes in the nature and reactivity of surface functional groups unique to that size range. The results imply that natural nanomaterials (<10 nm) can control the distribution of toxic metals in a different manner than that expected through consideration of the reactivity of larger particles, over and above the increased surface area.
Sobre Minerales y nanotecnología y más en estas actas de congreso
Nanomineralogy – low-cost nanotechnology of the future
Nanomineralogy at the Karlsruhe Research Center represents an interdisciplinary field of fundamental research and applied sciences with groups from different disciplines cooperating with partners from industry. This allows for the basic understanding of properties and the development of new technical applications that are oriented to meeting a real demand.
Our vision is to modify and tailor naturally occurring nanominerals as a low-cost basic material for new products.
Current activities in this direction therefore focus on clay minerals and hydroxides as the most abundant minerals on the Earth’s surface. Most of these minerals are of a size that is considered to be «nano». In nature, however, these nanomine-rals are aggregated and their properties are determined by the bulk material, e.g. clay. The first challenge now is to separate and delaminate the bulk material into fundamental particles and to preserve them as nanominerals. The overall objective is to use existing feedstock as an unlimited source of low-cost nanominerals.
Nanomineral extraction and the investigation of structural properties and interactions with other systems are the current research fields of nanomineralogy at the ITC-WGT. Mineral properties are defined on the nanoscale, most of them being very promising for technical applications in e.g. cosmetics, packaging, and construction materials.
Nowadays, understanding of nanominerals and their particular properties is rather limited. Production of new products requires knowledge of the mechanisms involved in the interaction of nanominerals with other materials , e.g. polymers. Final characteristics and properties of such nanocomposites also depend on the nanomineral-based substrate.
Another important aspect of nanotechnology is the formation of ordered structures on the nano to submicron level. Structuring processes, such as self-assembly and self-organization which create highly complex structures in nature, play an important role e.g. in crystallization and are subject of our research. Presently, these processes are being used in the nanostructuring of layer double hydroxides. Here, periodic structures are applied as templates for the formation of ordered structures on a higher level, e.g. proteins.
Our achievements include the chemical delamination of mica with divalent cations, the production of different kaolinite/polymer nanocomposites, and the magnetization of any non-magnetic material, e.g. TiO2, with nano-sized green rust in the form of aggregates.
At the Forschungszentrum Karlsruhe, a strong nanomine-ralogy group was established in early 2001 by a cooperation of universities, research facilities, and partners from industry.
David J. Vaughan1, Richard S. Cutting1,2,3,
Chris A. Muryn2 and Geoffrey T. Thornton2,4
1 Williamson Research Centre for Molecular Environmental Science, and Department of Earth Sciences,
3 Advanced Materials Research Institute,
4 Department of Chemistry,
Application of a combination of scanning probe microscopic and spectroscopic methods under highly controlled conditions is the key to understanding the reactivity of many mineral surfaces at the nanoscale, whether it be of small particles or larger crystals. The (111) surface of Fe3O4 (magnetite) provides an excellent example for detailed study. Our work shows that carefully prepared surfaces can exhibit four different kinds of termination, only one of which exposes both (uncapped) iron and oxygen atoms.
In addition to imaging freshly prepared magnetite surfaces, the reactivities of such surfaces have been explored using Scanning Tunneling Microscopy (STM), X-ray Photoelectron Spectroscopy (XPS) and Ultraviolet Photoelectron Spectroscopy (UPS) following exposure to H2O, HCOOH, C5H5N and CCl4. These studies enable both the validation of models of surface structure and the investigation of the mechanisms of reaction. The surface that exposes (uncapped) both iron and oxygen atoms is the most reactive to all of these molecules. The other surfaces exhibit reactive behaviour the relates to the presence of point defects.
Variable temperature STM studies, along with XPS and UPS investigations, of the reaction of magnetite with water vapour show limited reactivity at low exposures. Under higher water vapour exposures (100L of H2O) and isothermal isobaric conditions, the magnetite surface undergoes extensive hydroxylation. Spectra obtained at different pH2O show that both pressure and exposure level influence the onset of extensive dissociation of water on interaction with Fe3O4.
Y si queréis saber que es la nanomineralogía, pinchar aquí.
Y LAS IMAGENES
[…] “Etnoedafología y Conocimiento Campesino”. Así, por ejemplo, en las siguientes entregas: “Nanomundos, Nanominerales, Ciencias de la Tierra, Biosfera, Suelos y Nanoedafología” y “Arcillas, Suelo y Salud”, hablamos de la susodicha geomedicina, el poder curativo de […]